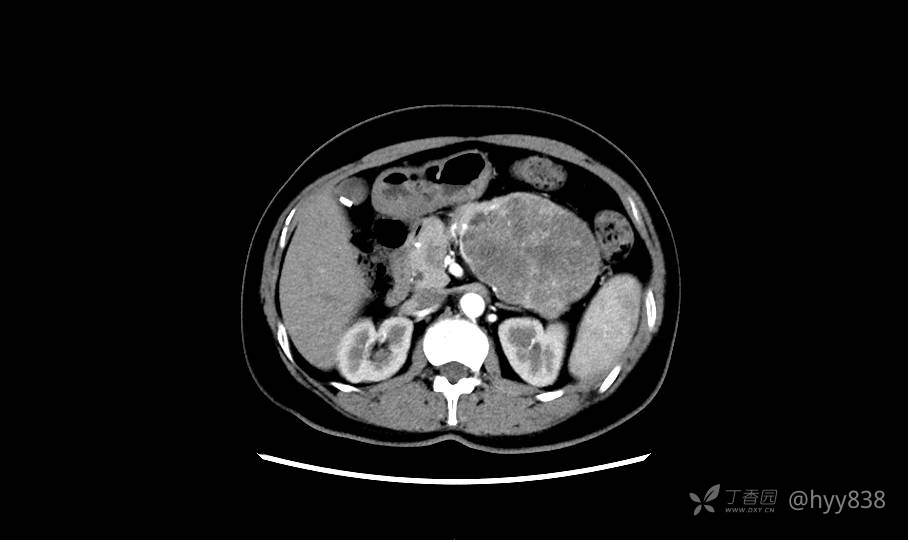
img

足够典型的胰腺尾部占位,影像即可拿下---结果公布~
患者性别:54岁
患者年龄:女
主诉:剑突下不适2周
简要病史:2周前,患者无明显诱因出现剑突下不适,以隐痛为主,无明显加重、缓解因素。门诊以胰腺巨大占位收入院进一步诊治。
体格检查:(-)
辅助检查:CT
临床诊断:胰腺占位
治疗经过:手术
讨论:病变影像特点和性质?
平扫是外院的,故没有平扫CT
胰腺增强动脉期











静脉期(机器故障---延迟期了)










患者性别:54岁
患者年龄:女
主诉:剑突下不适2周
简要病史:2周前,患者无明显诱因出现剑突下不适,以隐痛为主,无明显加重、缓解因素。门诊以胰腺巨大占位收入院进一步诊治。
体格检查:(-)
辅助检查:CT
临床诊断:胰腺占位
治疗经过:手术
讨论:病变影像特点和性质?
平扫是外院的,故没有平扫CT
胰腺增强动脉期

静脉期(机器故障---延迟期了)










